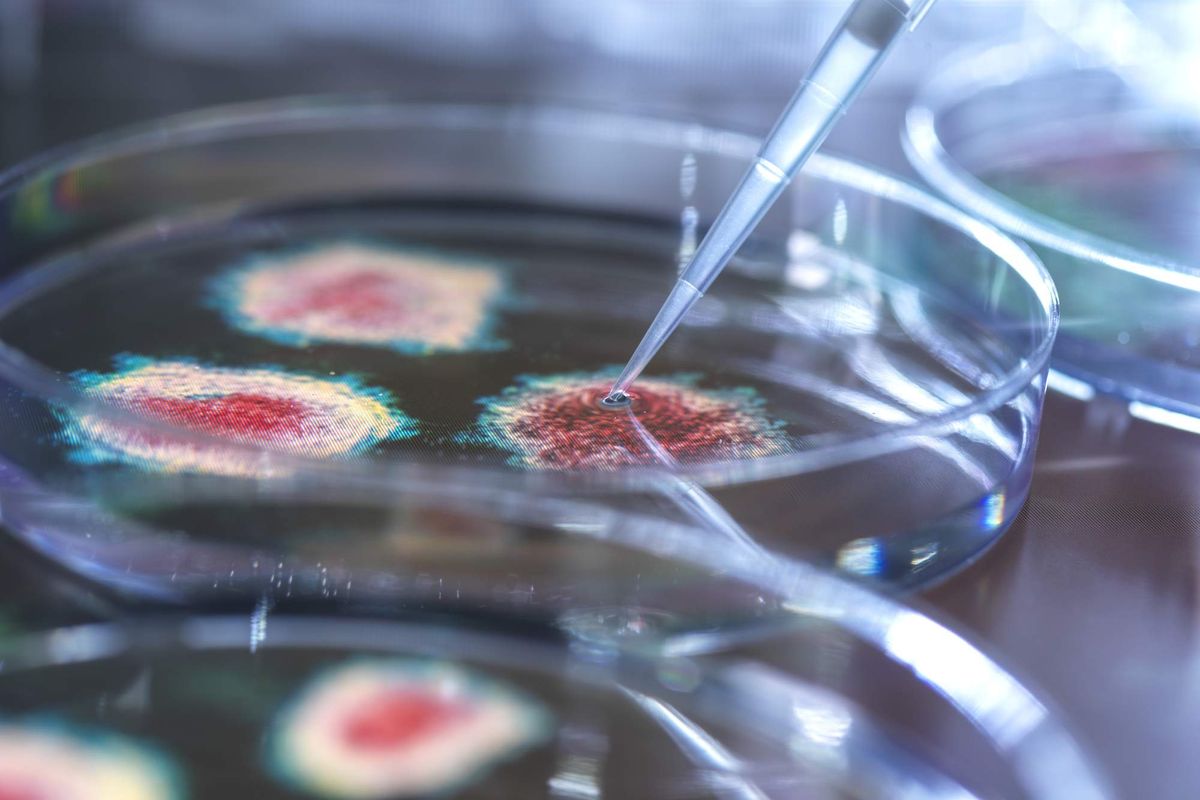

trending news
Houston health care innovation news lead this week's top stories
Editor's note: Let's roundup the most-read Houston innovation news from the week. Trending Houston tech and startup articles from InnovationMap and its daily newsletter included a new innovation leader at Houston Methodist, fresh funding for health tech, and more.
Houston Methodist names orthopedic surgeon as inaugural innovator in residency

Dr. Evan Collins, an orthopedic surgeon and chief of the Houston Methodist Hand & Upper Extremity Center, was named the hospital's first innovator in residency. Photo via drevancollins.com
Houston Methodist Center for Innovation has named its first innovator in residency.
Roberta Schwartz, executive vice president and chief innovation officer at Methodist, chose Dr. Evan Collins, an orthopedic surgeon and chief of the Houston Methodist Hand & Upper Extremity Center, for the role.
“Dr. Collins has been a physician champion for innovation projects over the past few years and will be an exceptional asset for our team to help involve physicians more actively in innovation throughout our hospital system,” Schwartz wrote on LinkedIn. Continue reading.
Houston hospital to establish genomics research hub as part of CPRIT's $60M round of grants

MD Anderson Cancer Center received $3 million to establish a new genomics research hub. Photo by F. Carter Smith/Courtesy of MD Anderson
Houston’s University of Texas MD Anderson Cancer Center will create a genomics research hub thanks to a nearly $3 million award from the Cancer Prevention and Research Institute of Texas, or CPRIT.
“This groundbreaking facility will have a profound impact on cancer research, and improving the diagnosis and treatment of cancer patients in Texas,” says CPRIT.
CPRIT gave the monetary award to Nicholas Navin, a professor at MD Anderson and at the biomedical sciences school within the University of Texas Health Science Center at Houston (UTHealth Houston). Continue reading.
Houston researchers advance unique nasal vaccine that prevents COVID transmission
The University of Houston's Navin Varadarajan explains that while COVID vaccines prevent advanced disease, they don’t prevent transmission. But he has a solution. Photo via Getty Images
Since the force of COVID-19 hit globally in 2020, scientists have made efficient progress in the fight against it. As Dr. Navin Varadarajan puts it, vaccines have “allowed us to become a society again.”
And he should know, the M.D. Anderson Professor of William A. Brookshire Chemical and Biomolecular Engineering at University of Houston just published back-to-back studies for nasal sprays that combat viruses. One, the NanoSTING therapeutic, has proven effective in treating strains of SARS-CoV-2 and the flu virus. The other, NanoSTING-NS Pan-coronavirus Vaccine is targeted at preventing the transmission of multiple COVID variants altogether.
Why a nasal vaccine? Varadarajan explains that while COVID vaccines prevent advanced disease, they don’t prevent transmission. Continue reading.
Houston oncology therapeutics co. raises $11.4M in seed funding

Diakonos Oncology Corp. closed its seed round to the tune of $11.4 million. Photo via Getty Images
A Houston-based, clinical-stage immuno-oncology company has raised an oversubscribed round of seed funding.
Diakonos Oncology Corp. closed its seed round to the tune of $11.4 million. The funding will go toward supporting the company's Phase 2 trial — slated for later this year, following its ongoing Phase 1 study — and operations through late next year. California-based biotechnology investment firm Restem Group Inc. led the round, and existing investors contributed as well.
“We greatly appreciate the support of these investors in sharing our passion for improving the lives of patients suffering from deadly cancers such as glioblastoma,” Mike Wicks, Diakonos CEO, says in a news release. “The fact that this financing is nearly triple our initial target also shows they share our confidence in the effectiveness of our unique cancer therapy.” Continue reading.
New study asserts Texas is the 2nd worst state for women's equality

The Lone Star State isn't shining bright when it comes to equality. Photo by Claudio Schwarz on Unsplash
Texas, WalletHub thinks we have a major equality problem. The Lone Star State has ranked at the bottom of the personal finance website's new nationwide analysis of gender equality.
The annual "Best & Worst States for Women's Equality" report, published August 19, ranked Texas No. 49 out of all 50 states where where women receive the most equal treatment in the U.S. Texas is accompanied in the bottom five by Utah (No. 50), Wyoming (No. 48), Idaho (No. 47), and Missouri (No. 46). Continue reading.
